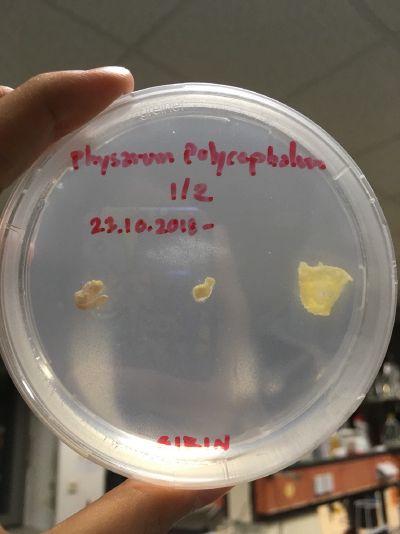
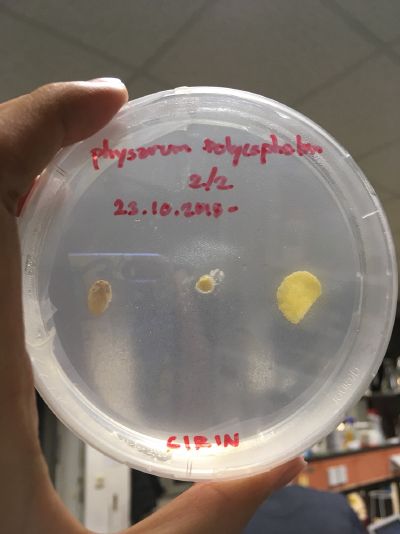

1st Experiment : 23.10.2018
Physarum polycephalum, often referred to as the “many-headed slime,” is a slime mold that inhabits shady, cool, moist areas, such as decaying leaves and logs. It is typically yellow in color, and eats fungal spores, bacteria, and other microbes. It shuns light, but light also triggers spore production. (source : [1])
The medium for the slime mold includes 2% agar and 98% still-water. For my experiment, I decided to add two types of food for each slime mold, oat and cornflake, to see which one that it prefers.
I experiment with two dishes. I place the first dish inside my wardrobe and place another dish on my heater.